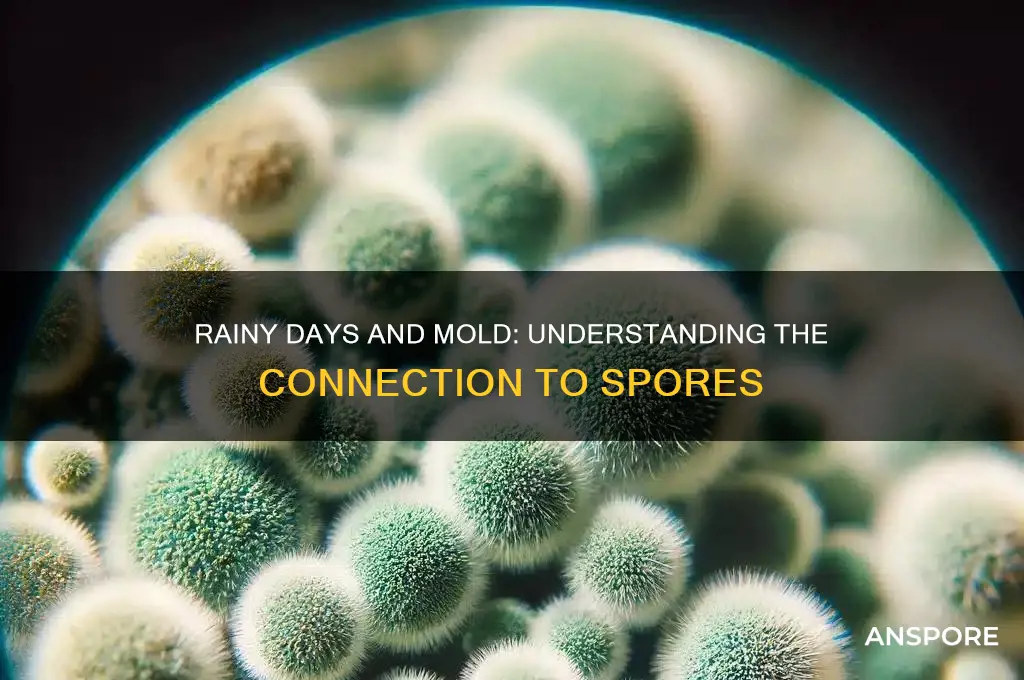
does alot of rainy days cause mold spores

Rainy days, while essential for ecosystems and agriculture, can create conditions conducive to mold growth, raising concerns about the proliferation of mold spores. Prolonged periods of rain increase humidity levels indoors and outdoors, providing the moisture mold needs to thrive. When surfaces remain damp for extended periods, mold spores, which are naturally present in the environment, can settle, germinate, and multiply rapidly. This is particularly problematic in poorly ventilated areas, where stagnant air traps moisture and fosters mold development. As a result, frequent rainy days can exacerbate mold-related issues, potentially leading to health problems such as allergies, respiratory issues, and other complications for individuals sensitive to mold spores. Understanding this relationship is crucial for implementing preventive measures, such as improving ventilation, reducing indoor humidity, and promptly addressing water damage, to mitigate the risks associated with mold growth during rainy seasons.
| Characteristics | Values |
|---|---|
| Correlation Between Rain and Mold Spores | Increased rainfall creates damp conditions, which are conducive to mold growth. Mold spores thrive in environments with high humidity (above 60%) and moisture. |
| Optimal Conditions for Mold Growth | Mold requires moisture, organic material (e.g., wood, paper, fabric), and temperatures between 68°F and 86°F (20°C and 30°C) to grow. |
| Impact of Prolonged Rain | Extended periods of rain can lead to water intrusion in buildings, leaky roofs, or poor drainage, creating persistent moisture that fosters mold spore proliferation. |
| Indoor vs. Outdoor Mold Spores | Rainy days increase outdoor mold spore counts, which can enter homes through open windows, doors, or HVAC systems, potentially causing indoor mold issues. |
| Health Risks | Elevated mold spore levels due to rain can trigger allergies, asthma, and respiratory issues in sensitive individuals. |
| Prevention Measures | Reducing indoor humidity (below 50%), fixing leaks, ensuring proper ventilation, and using dehumidifiers can mitigate mold growth during rainy periods. |
| Seasonal Patterns | Mold spore counts tend to peak during rainy seasons (e.g., spring and fall) due to increased moisture and organic debris. |
| Geographical Influence | Regions with high annual rainfall or humid climates (e.g., tropical areas) are more prone to mold issues during prolonged rainy periods. |
Explore related products
$13.48 $14.13
What You'll Learn

Impact of humidity levels on mold spore growth
Mold spores are ubiquitous in our environment, but their growth into visible colonies is heavily influenced by humidity levels. Relative humidity above 60% creates an ideal breeding ground for mold, as these microscopic organisms thrive in damp conditions. When moisture lingers in the air, whether from prolonged rainy periods or inadequate ventilation, it provides the necessary hydration for mold spores to germinate and proliferate. This is why homes in humid climates or those with water damage often struggle with mold infestations.
Consider the aftermath of a week-long rainy spell. Water seeps into porous materials like drywall, carpet, and wood, raising the local humidity. Without prompt drying, these areas become hotspots for mold growth. Even everyday activities like showering or cooking can contribute to elevated humidity if not properly managed. Using a hygrometer to monitor indoor humidity is a practical step; keeping levels below 50% can significantly deter mold development. Dehumidifiers and proper ventilation are essential tools in this battle, particularly in basements, bathrooms, and kitchens.
The relationship between humidity and mold is not just about water in the air; it’s about the balance of moisture and temperature. Warm, humid environments accelerate mold growth, as spores metabolize more rapidly in these conditions. For instance, a damp basement in summer can become a mold factory within days. Conversely, cold, humid environments may slow growth but still provide enough moisture for spores to survive until conditions improve. This highlights the importance of addressing both humidity and temperature in mold prevention strategies.
From a health perspective, understanding this relationship is crucial. Mold spores are allergens and can trigger respiratory issues, especially in sensitive individuals like children, the elderly, or those with asthma. Prolonged exposure to mold-infested environments can lead to chronic health problems. Thus, controlling humidity isn’t just about preserving property—it’s about safeguarding health. Regularly inspecting for leaks, ensuring proper insulation, and using mold-resistant materials in high-moisture areas are proactive measures that pay dividends in the long run.
In summary, humidity levels act as a catalyst for mold spore growth, turning dormant spores into active colonies. By maintaining optimal humidity, homeowners can disrupt this process and create an environment hostile to mold. It’s a simple yet powerful principle: control the moisture, control the mold. Whether through technological solutions like dehumidifiers or behavioral changes like prompt water cleanup, the key lies in vigilance and consistency. After all, prevention is far less costly than remediation.
Do Eukaryote Spores Have Seed Coats? Unraveling the Mystery
You may want to see also

How frequent rainfall affects indoor air quality
Frequent rainfall creates conditions that significantly impact indoor air quality, primarily by fostering mold spore proliferation. Mold thrives in damp environments, and prolonged wet weather increases indoor humidity levels, often exceeding the EPA-recommended range of 30-50%. When moisture seeps through leaks, condenses on surfaces, or is tracked indoors, it provides the ideal breeding ground for mold spores, which are naturally present in the air. These spores, when inhaled, can trigger allergic reactions, asthma attacks, and respiratory issues, particularly in children, the elderly, and immunocompromised individuals.
Consider a scenario where a home experiences three consecutive weeks of heavy rain. Without proper ventilation or dehumidification, moisture accumulates in basements, crawl spaces, and even wall cavities. Mold colonies can begin to form within 24-48 hours of water exposure, releasing millions of spores into the air. A study by the *Journal of Environmental Health* found that homes in regions with over 100 rainy days annually had mold spore counts 30-50% higher than those in drier climates. This highlights the direct correlation between rainfall frequency and indoor mold presence.
To mitigate these risks, homeowners should adopt proactive measures. First, invest in a dehumidifier to maintain indoor humidity below 50%. Regularly inspect and repair roof leaks, window seals, and plumbing issues to prevent water intrusion. After rainy periods, ventilate the home by opening windows and using exhaust fans, especially in moisture-prone areas like bathrooms and kitchens. For those in high-rainfall regions, consider using mold-resistant paints and materials during renovations. Additionally, HEPA air purifiers can help reduce airborne spore counts, particularly in bedrooms and living areas.
Comparatively, regions with infrequent rainfall face different challenges. In arid climates, mold is less of a concern, but dust and pollen dominate indoor air quality issues. However, even in these areas, sudden heavy rains can lead to temporary spikes in mold growth if homes are unprepared. This underscores the importance of universal preparedness, regardless of climate. For instance, a desert home experiencing rare flooding may see mold develop rapidly due to lack of preventive infrastructure, such as proper drainage or waterproofing.
In conclusion, frequent rainfall directly compromises indoor air quality by enabling mold spore growth, which poses health risks to occupants. By understanding the relationship between rain and mold, and implementing targeted strategies like dehumidification, ventilation, and regular maintenance, homeowners can safeguard their indoor environments. While climate plays a role, proactive measures are universally applicable, ensuring healthier living spaces even in the wettest conditions.
Can You Use Bonemeal on Spore Blossoms? A Minecraft Guide
You may want to see also

Mold spore proliferation in damp environments
Prolonged exposure to moisture creates ideal conditions for mold spore proliferation, as these microscopic fungi thrive in damp environments with relative humidity above 60%. Rainfall, especially when coupled with poor drainage or inadequate ventilation, introduces excess moisture into buildings, saturating porous materials like drywall, wood, and carpet. Within 24 to 48 hours, mold colonies can begin to form, releasing spores into the air as part of their reproductive cycle. This rapid growth underscores the urgency of addressing water intrusion after heavy or persistent rain.
Consider the mechanics of mold spore dispersal. Mold reproduces by releasing lightweight spores that travel through the air, seeking new surfaces to colonize. In damp environments, such as those created by leaky roofs, flooded basements, or poorly sealed windows, these spores find fertile ground. For instance, a single square inch of mold-infested material can release up to 10 million spores daily. This exponential growth not only accelerates structural damage but also poses health risks, particularly for individuals with allergies, asthma, or compromised immune systems.
To mitigate mold spore proliferation, proactive moisture control is essential. Start by identifying and repairing sources of water intrusion, such as cracked foundations, clogged gutters, or faulty plumbing. Use dehumidifiers to maintain indoor humidity below 50%, and ensure proper ventilation in high-moisture areas like bathrooms and kitchens. For materials that have been wet for more than 48 hours, removal and replacement are often necessary, as mold can penetrate deeply into porous surfaces. Non-porous materials, like glass or metal, can typically be cleaned with a solution of one cup of bleach per gallon of water, followed by thorough drying.
Comparing damp environments to drier ones highlights the stark difference in mold prevalence. In regions with frequent rainfall, such as the Pacific Northwest, mold-related issues are significantly more common than in arid climates like the Southwest. However, even in dry areas, localized dampness—from AC condensation or irrigation runoff—can create microenvironments conducive to mold growth. This comparison emphasizes that while climate plays a role, local conditions and human factors, such as building maintenance, are equally critical in preventing mold spore proliferation.
Finally, understanding the health implications of mold spores in damp environments reinforces the need for vigilance. Prolonged exposure can lead to respiratory issues, skin irritation, and even neurological symptoms in severe cases. Vulnerable populations, including children under 5, adults over 65, and immunocompromised individuals, are at heightened risk. Regular inspections, particularly after rainy seasons, can identify early signs of mold, such as musty odors or visible discoloration. By acting swiftly to eliminate moisture and mold, homeowners and renters can protect both their health and their property from the insidious effects of mold spore proliferation.
Do Dried Morels Retain Their Spores? Uncovering the Truth
You may want to see also
Explore related products

Rainy days and mold-related health risks
Prolonged rainy periods create damp environments that accelerate mold growth, significantly increasing spore counts indoors. Mold spores thrive in humidity levels above 60%, a threshold easily surpassed during extended wet weather. When inhaled, these spores can trigger allergic reactions, respiratory issues, and exacerbate conditions like asthma. For instance, a study in the *Journal of Allergy and Clinical Immunology* found that individuals in rainy climates were 30-50% more likely to experience mold-related symptoms compared to those in drier regions. This highlights the direct link between rainy days and heightened mold exposure.
To mitigate health risks, monitor indoor humidity with a hygrometer, aiming to keep levels below 50%. Use dehumidifiers in basements, bathrooms, and other moisture-prone areas. After heavy rain, inspect windows, roofs, and pipes for leaks, as even small water intrusions can foster mold colonies within 24-48 hours. For those with allergies or asthma, HEPA air filters can reduce spore circulation. Additionally, clean damp surfaces like shower walls and kitchen counters with a 1:8 bleach-to-water solution weekly to prevent mold buildup.
Children, the elderly, and immunocompromised individuals are particularly vulnerable to mold-related health issues. Symptoms to watch for include persistent coughing, sneezing, skin rashes, and eye irritation. If mold is visible or musty odors persist, professional remediation may be necessary, as DIY removal can disturb spores and worsen exposure. In severe cases, prolonged exposure to mold toxins (mycotoxins) can lead to chronic conditions like hypersensitivity pneumonitis, emphasizing the need for prompt action.
Comparing rainy and dry climates reveals stark differences in mold-related health outcomes. In regions like the Pacific Northwest, where annual rainfall exceeds 50 inches, mold-related doctor visits spike during wet seasons. Conversely, arid areas like Arizona report significantly lower mold-related illnesses. This contrast underscores the role of climate in mold proliferation and its health implications. For residents in rainy areas, proactive measures—such as waterproofing homes and using mold-resistant materials—are essential to safeguarding health.
In conclusion, while rainy days are unavoidable, their impact on mold growth and health risks can be managed. By controlling indoor humidity, addressing water damage promptly, and staying vigilant for early signs of mold, individuals can reduce exposure and protect their well-being. Understanding the relationship between weather patterns and mold proliferation empowers homeowners to take actionable steps, ensuring that rainy seasons don’t become a health hazard.
Can Fungal Spores Develop into Mature Hyphae? Unveiling the Process
You may want to see also

Preventing mold growth during prolonged wet weather
Prolonged wet weather creates ideal conditions for mold spores to thrive, as they flourish in damp, humid environments. Mold spores are ubiquitous, but excessive moisture indoors transforms them from dormant particles into active colonies. During extended rainy periods, water intrusion through leaks, poor ventilation, or high humidity levels becomes a catalyst for mold growth, posing health risks and structural damage. Understanding this relationship is the first step in mitigating the issue.
To prevent mold during prolonged wet weather, focus on moisture control. Start by fixing leaks immediately—even small drips can create pockets of dampness that mold exploits. Use dehumidifiers to maintain indoor humidity below 60%, and ensure they’re emptied regularly to prevent overflow. In areas prone to condensation, like bathrooms and kitchens, install exhaust fans or open windows to expel moist air. Regularly inspect basements, attics, and crawl spaces, as these are common problem areas due to poor airflow and hidden leaks.
Another critical strategy is to manage water around your home’s exterior. Ensure gutters and downspouts are clean and direct water at least 3 feet away from the foundation. Grade soil to slope away from the house, preventing water pooling near walls. During heavy rain, check for standing water and address it promptly. Inside, avoid carpeting in moisture-prone areas like basements, opting instead for mold-resistant materials like tile or concrete. If carpets get wet, dry them within 24–48 hours to prevent spore colonization.
Finally, proactive cleaning and monitoring are essential. Wipe down surfaces prone to moisture, such as windowsills and shower walls, with a solution of 1 cup bleach per gallon of water. Regularly inspect hidden areas like behind appliances and under sinks for early signs of mold. If mold appears, address it immediately—small patches (less than 10 square feet) can often be handled with DIY methods, but larger infestations require professional remediation. By staying vigilant and addressing moisture at its source, you can protect your home from mold even during the rainiest seasons.
Are Cubensis Spores Harmful to Dogs? A Safety Guide
You may want to see also
Frequently asked questions
Yes, prolonged rainy days can increase moisture levels indoors and outdoors, creating ideal conditions for mold spores to grow and thrive.
Rainy days raise humidity levels, and when moisture accumulates in damp areas like walls, carpets, or wood, it provides a breeding ground for mold spores to develop and spread.
Yes, if moisture remains in a space after rainy days, mold spores can continue to grow and multiply, posing health risks and causing damage to surfaces.
Yes, areas with poor ventilation, leaks, or high humidity, such as basements, bathrooms, and attics, are more susceptible to mold growth during prolonged rainy periods.
Reduce indoor humidity with dehumidifiers, fix leaks promptly, ensure proper ventilation, and clean damp areas thoroughly to prevent mold spores from taking hold.































